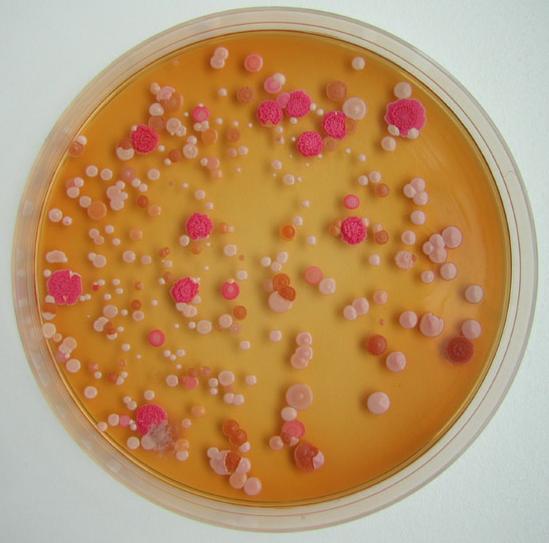
检验美学之菌落鉴赏_微生物检验_实验技术

微生物图片菌落

微生物菌落.jpg
图片尺寸1444x1221
想问下平板中那几个呈黄色的菌落是什么菌 - 食品微生物检测 - 食品
图片尺寸800x1068
微生物菌落形态特征辨别
图片尺寸1840x3264
69 食品微生物检测 69 在琼脂平板上面长得油滴状,粘性,凸起,菌落
图片尺寸4000x3000
食品实验室管理区≡ 69 食品微生物检测 69 霉菌分类之菌落观察
图片尺寸950x605
首页 食品微生物学 第二章 原核微生物 第一节 细菌 >> 细菌的菌落
图片尺寸875x802
四种颜色的细菌菌落在琼脂平板上,在黑色背景上分离
图片尺寸1106x1100
药品需氧菌总数菌落有点奇怪 - 食品微生物检测 - 食品论坛 - powered
图片尺寸1080x1440
水质的菌落总数 - 食品微生物检测 - 食品论坛 - powered by discuz!
图片尺寸2592x1944
细菌菌落在琼脂平板上分离为黑色
图片尺寸1104x1100
食品微生物检测 - 食品论坛 - powered by discuz!
图片尺寸2938x3917
【资源】发现一个细菌菌落精彩照片的新网站
图片尺寸640x512
帮忙看一下这是什么菌落 - 食品微生物检测 - 食品论坛 - powered by
图片尺寸1024x768
菌落形态确认 - 食品微生物检测 - 食品论坛 - powered by discuz!
图片尺寸3120x4160
检验美学之菌落鉴赏_微生物检验_实验技术
图片尺寸549x543
炎costandinsurance成本加保险价在显微镜下培养皿上的细菌菌落在黑色
图片尺寸317x300
绿色的真菌菌落在黑色的琼脂平板上分离出来
图片尺寸1116x1100
谢谢 - 食品微生物检测 - 食品论坛 - powered by discuz!
图片尺寸2592x1944
培养皿上的细菌菌落
图片尺寸1162x1100
论坛 69 ≡食品实验室管理区≡ 69 食品微生物检测 69 菌落总数
图片尺寸1280x960